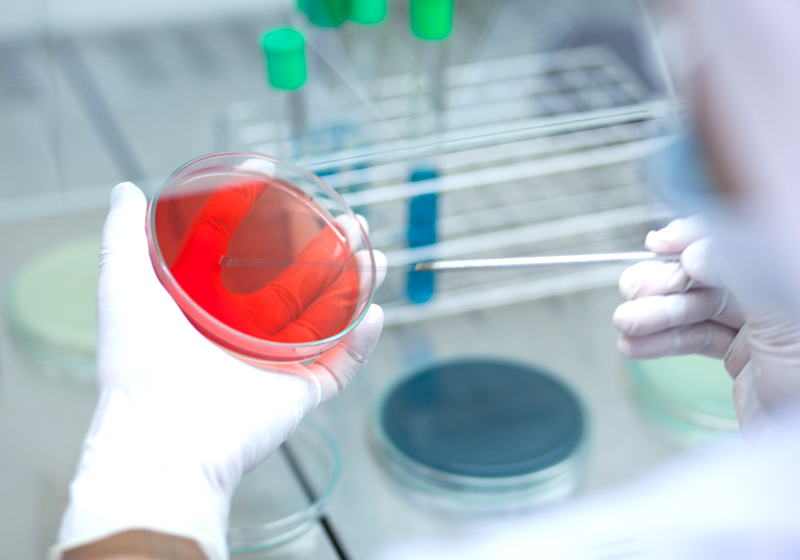

Creativity & Innovation
” เพราะพลังความคิดสร้างสรรค์และนวัตกรรม คือฟันเฟืองที่จะขับเคลื่อน พาองค์กรไปสู่ความเป็นผู้นำและความสำเร็จอย่างยั่งยืน “
GSL จึงมีนโยบายที่มุ่งเน้นการพัฒนาธุรกิจบนพื้นฐานของความสร้างสรรค์และนวัตกรรมอย่างต่อเนื่อง โดยเรามีทีมงานค้นคว้าวิจัยที่มีความรู้และประสบการณ์สูง อุปกรณ์การทดลองและห้องปฏิบัติการทางวิทยาศาสตร์ที่ทันสมัยและครบวงจร
และมีการร่วมมือกับสถาบันการศึกษาชั้นนำของประเทศ เพื่อทำการค้นคว้าและพัฒนาผลิตภัณฑ์ใหม่ๆ นอกจากนี้ เรายังมี Technical lab ที่ประเทศสิงคโปร์ และทีมเทคนิคที่พร้อมให้คำปรึกษา ต่อยอดความคิดเพื่อสร้างสรรค์ผลิตภัณฑ์ที่มีคุณภาพ ที่สามารถตอบสนองความต้องการของลูกค้าได้อย่างสูงสุด